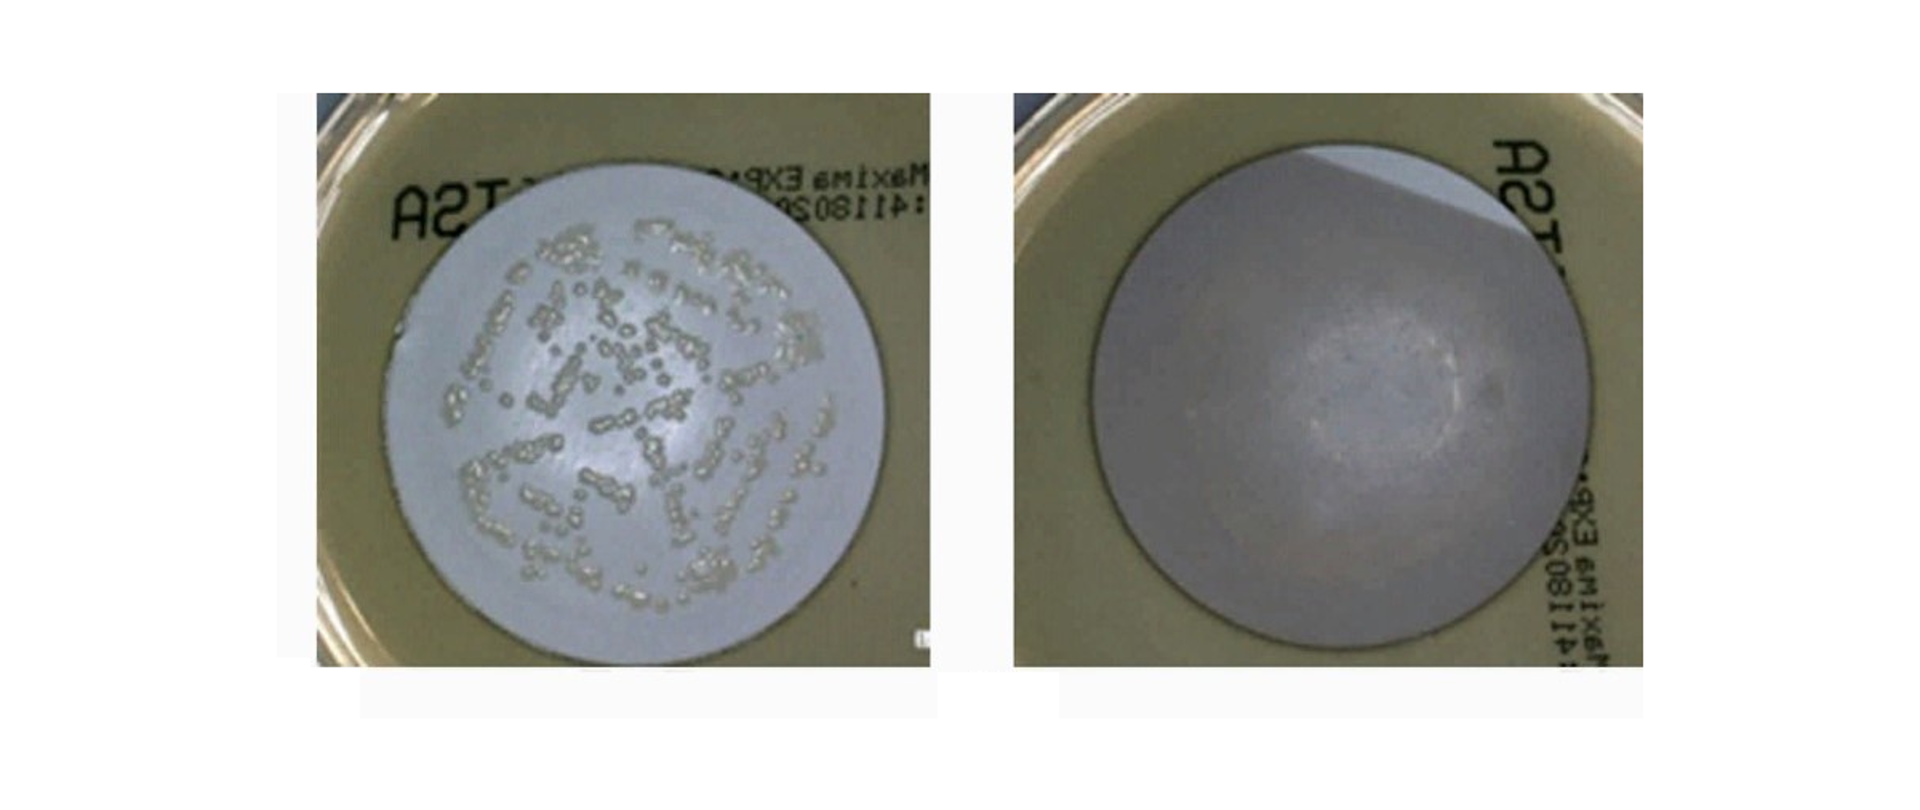
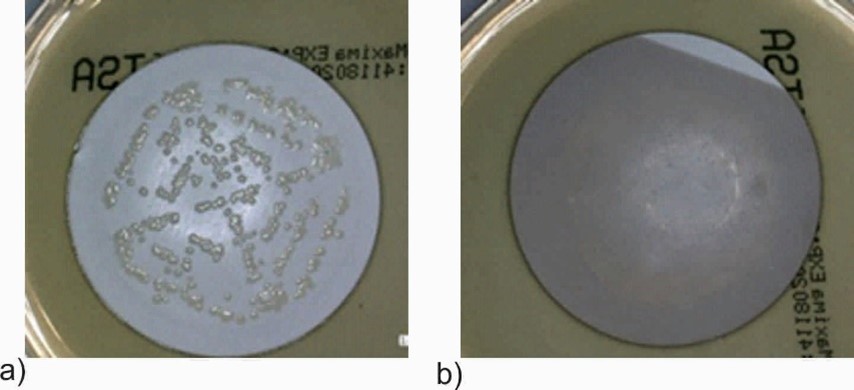

Multifunkcjonalne membrany polimerowe
Polimerowe membrany mikrofiltracyjne są szeroko stosowane w procesach filtracji ścieków w przemyśle mleczarskim i umożliwiają wprowadzenie w tym obszarze gospodarki obiegu zamkniętego
Tytuł projektu
Tytuł projektu
Multifunkcjonalne membrany polimerowe modyfikowane z wykorzystaniem hybrydowych technologii inżynierii powierzchni
 Nazwa Beneficjenta/Beneficjentów
Nazwa Beneficjenta/Beneficjentów
Sieć Badawcza Łukasiewicz – Instytut Technologii Eksploatacji
 Nazwa programu
Nazwa programu
Programy krajowe
 Konkurs
Konkurs
LIDER VII
 Wartość projektu
Wartość projektu
688 000,00 PLN
 Wartość dofinansowania
Wartość dofinansowania
688 000,00 PLN
 Okres realizacji projektu
Okres realizacji projektu
od 01.01.2017 r. do 31.12.2020 r.
Poznajcie nasz zespół
Kierownik Projektu - Dr inż. Joanna Kacprzyńska-Gołacka
mgr inż. Wioletta Barszcz
dr inż. Anna Kowalik-Klimczak
dr inż. Monika Łożyńska
mgr inż. Paulina Rajewska
mgr inż. Jarosław Skowroński
mgr Ewa Woskowicz
dr inż. Piotr Wieciński
Zobacz efekt naszej pracy

Jaki problem rozwiązuje nasz projekt?
Polimerowe membrany mikrofiltracyjne są szeroko stosowane w procesach filtracji ścieków w przemyśle mleczarskim i umożliwiają wprowadzenie w tym obszarze gospodarki obiegu zamkniętego. Obecnie głównym ograniczeniem w stosowaniu membran polimerowych w procesach filtracji jest zjawisko biofoulingu, polegające na zasiedlaniu powierzchni oraz porów membran przez mikroorganizmy. W wyniku tego zjawiska następuje istotny spadek wydajności procesu filtracji.
Głównym celem projektu było opracowanie modelowej technologii obróbki powierzchniowej umożliwiającej wytworzenie wielofunkcyjnej membrany charakteryzującej się bardzo dobrymi właściwościami hyrdrofilowymi oraz wysoka aktywnoscią bakteriobójczą.
Opracowane w projekcie rozwiązania procesowe umożliwiają modyfikację właściwości funkcjonalnych membran filtracyjnych, co prowadzi do ograniczenia zjawiska biofoulingu, a co za tym idzie zwiększenia wydajności procesu filtracji.
Unikatowe właściwości membran zostały uzyskane przy wykorzystaniu nowoczesnych plazmowych technik inżynierii powierzchni. Pierwsze z opracowanych rozwiązań obejmuje aktywację powierzchni polimeru w plazmie wyładowania jarzeniowego. Opracowana technologia umożliwia poprawę właściwości filtracyjnych poprzez zwiększenie hydrofilowości powierzchni membrany. Ponadto opracowana aktywacja plazmą niemetaliczną zapewnia poprawę reaktywności chemicznej membrany, co umożliwia dalsze wprowadzenie pierwiastków i związków chemicznych na jej powierzchnię.
Drugim z opracowanych rozwiązań jest nadanie właściwości funkcjonalnych membranie polimerowej poprzez nałożenie cienkiej wieloskładnikowej powłoki na bazie tlenku tytanu oraz tlenku srebra (TiO2+AgO), która z jednej strony nie powoduje zablokowania porowatej struktury membrany, a tym samym nie zmienia jej właściwości filtracyjnych, a z drugiej strony umożliwia nadanie właściwości fotokatalitycznych, hydrofilowych i przede wszystkim bakteriobójczych.
Kto korzysta/skorzysta z wyników projektu?
Rezultatem zrealizowanych prac badawczych jest rozwiązanie materiałowo-technologiczne z obszaru inżynierii powierzchni, zapewniające poprawę efektywności membran polimerowych stosowanych w procesach filtracji ścieków mleczarskich. Opracowane rozwiązanie materiałowe umożliwia wzbogacanie komercyjnych materiałów membranowych o dodatkowe właściwości funkcjonalne. Uzyskane rozwiązania materiałowo-technologiczne mają duże znaczenie ekonomiczne dla przedsiębiorstw wykorzystujących procesy filtracji membranowej. Możliwości wykorzystania w praktyce opracowanych membran nowej generacji są bardzo szerokie. Poddając obróbce powierzchniowej membrany istniejące na rynku nie zmieniamy ich parametrów geometrycznych co sprawia, iż mogą one być stosowane w przemyśle w istniejących modułach i instalacjach filtracyjnych.
Co było dla nas największym wyzwaniem w projekcie?
Największym wyzwaniem był wybór technologii plazmowej modyfikacji membran oraz dobór parametrów technologicznych procesu. Materiały polimerowe, z których wykonane są membrany, charakteryzują się niską odpornością termiczną nieprzekraczająca, 100ºC. Dodatkowo membrany polimerowe posiadają porowatą strukturę, która ma istotne znaczenie w procesie filtracji i musi zostać zachowana po etapie obróbki powierzchniowej.
W związku z tym istniało duże ryzyko przegrzania membrany w procesie obróbki plazmowej, co mogło spowodować uszkodzenie jej porowatej struktury i pogorszenie lub utratę właściwości separacyjnych. Ponadto wytwarzanie powłok metalicznych metodami plazmowymi w temperaturze poniżej 100ºC mogło mieć niekorzystny wpływ na zachowanie stabilności i ciągłości osadzanych powłok oraz ich przyczepności do podłoża.
Wybrana w projekcie technologia rozpylania magnetronowego umożliwia osadzanie powłok w temperaturze pokojowej, co pozwoliło na modyfikację membran bez uszkodzenia ich struktury.